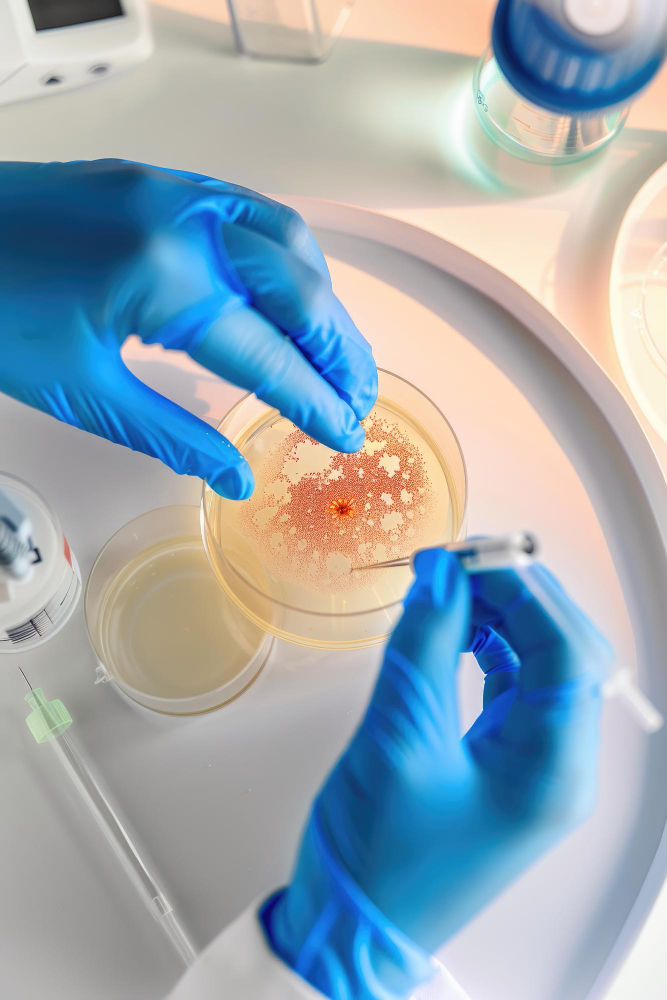
sperm prepration

IUI (Intrauterine Insemination)
Safe, Simple & Effective Fertility Treatment
If you have been trying to conceive naturally without success, IUI (Intrauterine Insemination) can be a safe, minimally invasive, and affordable fertility treatment option. Under the expert guidance of Dr. Priyanka Bhadana, couples receive personalized IUI treatment based on evidence-based protocols and global best practices.
With over 15 years of experience in Obstetrics & Gynaecology and 9+ years dedicated exclusively to infertility, Dr. Priyanka offers ethical, transparent, and patient-centric fertility care
IUI is a fertility treatment in which processed and concentrated sperm is directly placed inside the woman’s uterus during ovulation. This increases the chances of fertilization by bringing healthy sperm closer to the egg.
It is often recommended as the first-line treatment before moving to advanced procedures like IVF.
Who Should Consider IUI?
IUI may be recommended in the following cases:
Mild male factor infertility (low sperm count or motility)
Unexplained infertility
Ovulation disorders
PCOS-related infertility
Cervical factor infertility
Sexual dysfunction or ejaculatory issues
Dr. Priyanka carefully evaluates both partners before recommending IUI to ensure the highest possible success rate.
IUI Procedure – Step-by-Step Process
Step 1: Detailed Fertility Evaluation
Hormonal tests, ultrasound, semen analysis, and ovulation assessment.
Step 2: Ovulation Monitoring
Follicular monitoring through ultrasound to track egg development.
Step 3: Ovulation Trigger
When the follicle reaches optimal size, ovulation is triggered.
Step 4: Sperm Preparation
The semen sample is washed and processed in the lab to select highly motile sperm.

Step 5: Insemination Procedure
A thin catheter is used to place the prepared sperm directly into the uterus.
The procedure is painless and takes only 5–10 minutes.
Why Choose IUI Treatment with Dr. Priyanka?
Individualized stimulation protocols
Advanced follicular monitoring
Evidence-based medicine approach
Ethical and transparent treatment
Comfortable and supportive environment
Experienced IVF & fertility specialist
Her experience in handling complex infertility cases ensures proper patient selection for IUI, improving overall outcomes.
Benefits of IUI
- Less invasive than IVF
- More affordable fertility treatment
- Minimal discomfort
- Short procedure time
- Natural fertilization process
- No anesthesia required
When to Move from IUI to IVF?
If pregnancy does not occur after 3–4 well-monitored IUI cycles, advanced treatments like IVF may be advised, especially in cases of:
- Severe male factor infertility
- Low ovarian reserve
- Blocked fallopian tubes
- Recurrent IUI failures

Frequently Asked Questions
Generally, 3–4 cycles are advised before considering IVF.
Yes, IUI can be performed in natural cycles or with mild ovarian stimulation depending on the case.
No strict bed rest is required. Normal routine activities can be resumed the same day.
